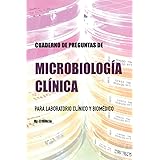

Cuaderno laboratorio

 Comprar
Comprar Boorum & Pease Cuaderno especial de laboratorio, rayido para registro, negro, 150 páginas, 10-3/8" x 8-1/8" (L21-150-R)

 Comprar
Comprar Cuaderno de Notas la Mejor Fisioterapeuta del Mundo - Libreta de Madera Natural con Boligrafo Regalo Original Tamaño A5
![Logix Books® GLP Laboratory Notebook/Cuaderno de Laboratorio, A4, Rayado (5mm), Azul, 96 páginas, Encuadernación cosida, (LOGIX-A4R-096-R) [Tapa Dura]](https://m.media-amazon.com/images/I/91HhB6ne7ML._AC_SY606_.jpg)
 Comprar
Comprar Logix Books® GLP Laboratory Notebook/Cuaderno de Laboratorio, A4, Rayado (5mm), Azul, 96 páginas, Encuadernación cosida, (LOGIX-A4R-096-R) [Tapa Dura]

 Comprar
Comprar Cuaderno de apuntes de laboratorio de biología, autocopiativo de BookFactory, 25 páginas (21,5 x 28 cm) (páginas de transferencia) páginas de ...

 Comprar
Comprar Learning Resources- Increíble Laboratorio de microbios y Cuaderno de Notas sobre los gérmenes de Nancy Bs Science Club, Color (EI-5362)
Desglosando Cuaderno laboratorio
¿Usas Cuaderno laboratorio en tu cada día? El cuaderno cuadriculado es la opción más elegida en el día a día de mucha gente. Su base de cuadraditos permite escribir de una forma recta y ordenada. En oficinas o institutos, si se precisa hacer cuentas a mano, la opción mejor es un cuaderno cuadriculado.
A los entusiastas de la saga de Harry Potter, les encantaría ir a clase con uno de sus cuadernos. Hay cientos y cientos de diferentes cuadernos: vintage, tapa dura, tapa blanda, cuadriculado, punteado... ¡Regálaselo a ese amigo tan fan de Harry Potter!
Un bloc de notas inteligente es buena opción si te agrada redactar a mano, pero necesitas que tus contenidos se guarden en un espacio seguro como la nube. Esta clase de cuadernos guarda de forma digital todo lo que escribas, por lo que no ocupará ningún espacio físico.
Death note es una serie de anime. La historia de la serie gira ambiente a un bloc de notas con poderes sobrehumanos que es capaz de matar a la gente. Death note cuaderno es un bloc de notas negro donde apuntan el nombre de la persona que quieren matar.
El cuaderno dibujo a4 es muy empleado por personas que se dedican al dibujo. Dependiendo de la técnica que se usará, son mejores unos cuadernos que otros en tanto que si se emplea la acuarela es mejor emplear un papel grueso que absorba el agua, y si se utiliza tinta es mejor un papel fino.
Tener un bloc de notas bonito motiva mucho más que cualquier bloc de notas básico. De ahí que es esencial escoger un bloc de notas que nos guste para que toda vez que debamos hacer apuntes estemos ilusionados por redactar en él. Un bloc de notas bonito se cuida mejor.
Cuadernos Lamela es una marca fácil que crea cuadernos dirigidos a pequeños que aprenden a escribir o para prosperar su escritura. Estos cuadernos muestran donde debes escribir. Tienen varios formatos dirigidos a diferentes edades como el cuaderno lamela 4mm que esta dirigido a pequeños entre siete y 9 años.
La acuarela es una técnica de pintura que no se puede plasmar sobre cualquier papel puesto que puede traspasar el papel. El cuaderno acuarela tiene más resistencia a la ondulación que provoca la acuarela, gracias a su composición de sus fibras de algodón.
El bloc de notas hojas negras es utilizado para dar a nuestros apuntes o bien nuestro dibujos un toque original. Se trata de un bloc de notas normal cuyo interior está repleto de hojas negras, en el que se debe redactar con tinta blanca o bien colores que no sean oscuros para que se puedan apreciar.
Hoy en día prácticamente todo el planeta intenta reciclar y volver a usar lo máximo posible para reducir el impacto medioambiental. Y para eludir el uso del papel, crearon los cuadernos reutilizables, los cuales pueden borrarse sin dificultad y ser de nuevo usados.
El cuaderno pentagrama es el sistema estándar de anotación musical, que usa la gente que se dedica a la música para saber la partitura que debe interpretar. Este cuaderno está lleno de pentagramas a fin de que se puedan apuntar las partituras necesarias.
El bloc de notas oxford tapa dura evita que las esquinas se estropeen y el bloc de notas se vea más ordenado. Su tapa dura hace que se pueda escribir sobre el sin necesidad de tener nada de apoyo. Los estudiantes eligen Cuaderno laboratorio como top 1 en cuadernos.
Seguramente la gran mayoría ha debido hacer algún bloc de notas rubio en el instituto y en las vacaciones veraniegas. Estos cuadernos se dirigen a los pequeños de la casa para practicar la escritura y la lectura además de ayudar a la memoria.
Una de las marcas de cuadernos más utilizadas por los estudiantes es la de cuaderno Oxford. ¿Conoces Cuaderno laboratorio? Estos cuadernos tienen un papel blanco de buenísima calidad en el que la tinta no traspasa y además de esto tiene un tacto muy suave.